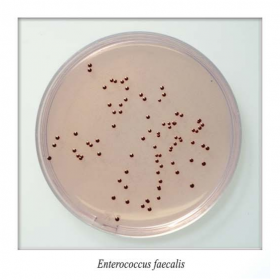
Энтерококкагар
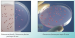
Энтерококкагар

Энтерококкагар
Энтерококкагар сухой
Питательная среда для выделения энтерококков из клинического материала, воды, пищевых продуктов и других объектов.
Данный продукт имеет Регистрационное Удостоверение.
Фасовка 250 г для приготовления 8 л среды.
Срок годности 2 года.
- Стерильность: -
- Форма выпуска: Порошок
- Упаковка: 250 г
- Документы: Регистрационное Удостоверение